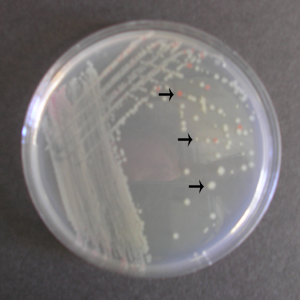

Anton de Bary wrote what about bacteria?
that these shapes form the characteristic features for the recognition and and differentiation of species. This resulted in the study of the single cell - the pure culture approach.
What is a pure culture?
consists of only one species of microorganism
What were the earliest methods of obtaining a pure culture?
inoculating the small amounts of a sample taken from a diseased animal into a flak of blood. The microbes were transferred from flask to flask until only one microbe was seen.
The next development of using agar to solidify samples came from whose lab?
Robert Koch
The next development came when the Difco (Differential Ferments Company) began produciing enzymes to help with?
digestion
Difco used enzymes to help digest _____________?
proteins
What as in the first solid media culture?
peptone and agar
What is the role of the peptone?
furnishes nitrogenous food in the form of amino acids and also a pH buffer substance in the form of phosphate salts
Name the 3 dilution methods used to for isolating bacteria.
1. the streak plate
2. the spread plate
3.pour plate
Streak plate technique
A loop is used to streak the mixed sample many times over the surface of a solid culture medium in a Petri plate. Theoretically the the process of streaking the loop repeatedly over the agar surface causes the bacteria to fall off the loop one by one and ultimately to be distributed over the agar surface where each cell develops into a colony.
Which is the most common isolation technique?
streak plate
Which plate technique are quantitative?
spread plate and pour plate
How can the number of bacteria in a sample be determined?
counting the number of colony-forming units
True or false. The sample must be diluted because even a milliliter of of milk or water could yield 20,000 colonies, too many to count.
true
A series of ________ is made and cultured because you don't know the _______ of bacteria in a sample.
dilutions
number
Spread plate technique is _________________________.
A small amount of a previously diluted specimen is spread over the surface of a solid medium using a spread rod.
In the pour plate technique a _____________________________.
Small amount of diluted sample is mixed with melted agar and poured into an empty sterile Petri dish. After incubation bacterial growth is visible as colonies in and on the agar of of a pour plate.
What is the number of bacteria used for an original sample of a pour plate?
between 25 and 250 colonies is selected
True or false. Fewer than 25 colonies is inaccurate because a single contaminant causes at least a 4% error.
true
The number of bacteria in the original sample is calculated as:
Colony-forming units Number of colonies
_____________________
per ml = Dilution*X Amount plated
Is this a mixed culture streak plate?
yes

Is this a subculture streak plate?
yes
This technique involves streaking four sides of a plate, sterlizing the loop between each quadrant and reinoculating it by touching an edge of each quadrant and dragging it to streak the next
streak plate technique
How do you know if you have isolated one bacterium in the streak plate technique?
There should only be one type of colony
What is a contaminant?
unwanted organism
How would you determine whether a colony was a contaminant on a streak plate?
A contaminant would be one growing in an area where you did not streak
How would you determine whether a colony was a contaminant on a pour plate?
By looking at the appearance of the colonies to see if there is one that looks different
What would happen if a streak plate was incubated for a week longer than it was supposed to be?
There would be so many colonies growing that none would be isolated
What is a disadvantage of the streak plate technique?
You have to be very careful with your streaking to avoid getting groups of cells close that look like a colony but are really multiple types of bacteria
What is a disadvantage of the pour plate technique?
It is difficult to isolate aerobes
Will the isolated colonies always be in the fourth sector on a streak plate?
Not necessarily; you could get them in the third but usually the fourth